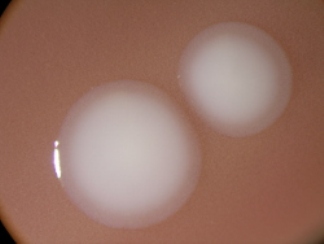

Probada con éxito en cabras una nueva vacuna contra la tuberculosis
Investigadores del CReSA prueban por primera vez y con éxito una nueva vacuna contra la tuberculosis que mejora la protección de la única vacuna existente en la actualidad, cuya eficacia es bastante limitada.